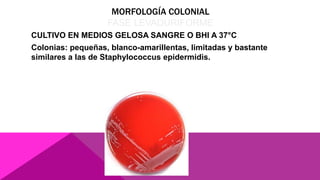
MORFOLOGÍA COLONIAL
FASE LEVADURIFORME
CULTIVO EN MEDIOS GELOSA SANGRE O BHI A 37°C
Colonias: pequeñas, blanco-amarillentas, limitadas y bastante
similares a las de Staphylococcus epidermidis.

La histoplasmosis es una infección causada por el hongo dimórfico Histoplasma capsulatum. Generalmente se inicia en los pulmones y puede diseminarse a otros órganos. Los síntomas van desde leves como una gripe hasta graves como neumonía. El diagnóstico se realiza mediante el examen microscópico de muestras, cultivo del hongo o pruebas serológicas e inmunológicas.